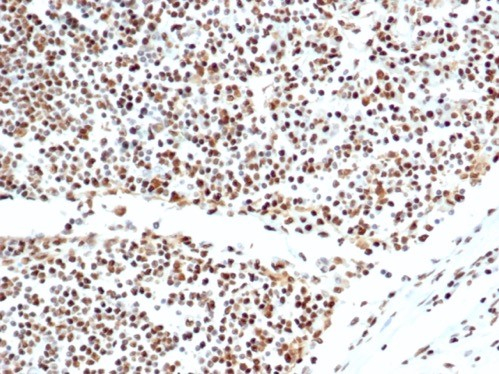
Ku80/XRCC5 Antibody (XRCC5/7317) - Azide and BSA Free

346 results for "Ku80/XRCC5" in Products
Ku80/XRCC5 Products
The Ku70 and Ku80 proteins are part of the DNA-Dependent Protein Kinase (DNA-PK). The Ku proteins are the DNA-binding components of the complex, while DNA-PK Catalytic Subunit (DNA-PKCS) is the active kinase.
Catalog #:
NBP3-14017AFP594
| Reactivity: | Human |
| Details: | Mouse IgG1 kappa Monoclonal Clone #XRCC5/7315 |
| Applications: | IHC, WB |
| Reactivity: | Human |
| Details: | Mouse IgG1 kappa Monoclonal Clone #XRCC5/7317 |
| Applications: | IHC, WB |
| Reactivity: | Human |
| Details: | Mouse IgG1 Kappa/IgG2b Kappa Monoclonal Clone #XRCC5/7316 |
| Applications: | IHC, WB |
| Reactivity: | Human |
| Details: | Mouse IgG1 kappa Monoclonal Clone #XRCC5/7315 |
| Applications: | IHC, WB |
| Reactivity: | Human |
| Details: | Mouse IgG1 kappa Monoclonal Clone #XRCC5/7315 |
| Applications: | IHC, WB |
| Reactivity: | Human |
| Details: | Mouse IgG1 Kappa/IgG2b Kappa Monoclonal Clone #XRCC5/7316 |
| Applications: | IHC, WB |
| Reactivity: | Human |
| Details: | Mouse IgG1 kappa Monoclonal Clone #XRCC5/7317 |
| Applications: | IHC, WB |
| Reactivity: | Human |
| Details: | Mouse IgG1 kappa Monoclonal Clone #XRCC5/7314 |
| Applications: | IHC, WB |
| Reactivity: | Human |
| Details: | Mouse IgG1 kappa Monoclonal Clone #XRCC5/7314 |
| Applications: | IHC, WB |
Recombinant Monoclonal Antibody
| Reactivity: | Human |
| Details: | Rabbit IgG1 kappa Monoclonal Clone #XRCC5/8703R |
| Applications: | IHC |
Recombinant Monoclonal Antibody
| Reactivity: | Human |
| Details: | Rabbit IgG1 kappa Monoclonal Clone #XRCC5/8703R |
| Applications: | IHC |
Recombinant Monoclonal Antibody
| Reactivity: | Human |
| Details: | Rabbit IgG1 kappa Monoclonal Clone #XRCC5/8093R |
| Applications: | IHC |
Recombinant Monoclonal Antibody
| Reactivity: | Human |
| Details: | Rabbit IgG1 kappa Monoclonal Clone #XRCC5/8093R |
| Applications: | IHC |
Recombinant Monoclonal Antibody
| Reactivity: | Human |
| Details: | Rabbit IgG1 kappa Monoclonal Clone #XRCC5/8703R |
| Applications: | IHC |
| Reactivity: | Human |
| Details: | Mouse IgG1 kappa Monoclonal Clone #XRCC5/7315 |
| Applications: | IHC, WB |
| Reactivity: | Human |
| Details: | Mouse IgG1 Kappa/IgG2b Kappa Monoclonal Clone #XRCC5/7316 |
| Applications: | IHC, WB |
| Reactivity: | Human |
| Details: | Mouse IgG1 kappa Monoclonal Clone #XRCC5/7314 |
| Applications: | IHC, WB |
| Reactivity: | Human |
| Details: | Mouse IgG1 kappa Monoclonal Clone #XRCC5/7317 |
| Applications: | IHC, WB |
| Reactivity: | Human |
| Details: | Mouse IgG1 kappa Monoclonal Clone #XRCC5/7314 |
| Applications: | IHC, WB |
| Reactivity: | Human |
| Details: | Mouse IgG1 Kappa/IgG2b Kappa Monoclonal Clone #XRCC5/7316 |
| Applications: | IHC, WB |
Recombinant Monoclonal Antibody
| Reactivity: | Human |
| Details: | Rabbit IgG1 kappa Monoclonal Clone #XRCC5/8703R |
| Applications: | IHC |
Recombinant Monoclonal Antibody
| Reactivity: | Human |
| Details: | Rabbit IgG1 kappa Monoclonal Clone #XRCC5/8093R |
| Applications: | IHC |
| Reactivity: | Human |
| Details: | Mouse IgG1 kappa Monoclonal Clone #XRCC5/7317 |
| Applications: | IHC, WB |
Recombinant Monoclonal Antibody
| Reactivity: | Human |
| Details: | Rabbit IgG1 kappa Monoclonal Clone #XRCC5/8703R |
| Applications: | IHC |
Recombinant Monoclonal Antibody
| Reactivity: | Human |
| Details: | Rabbit IgG1 kappa Monoclonal Clone #XRCC5/8093R |
| Applications: | IHC |

![Western Blot: Ku80/XRCC5 Antibody (XRCC5/7317) [NBP3-13796] Western Blot: Ku80/XRCC5 Antibody (XRCC5/7317) [NBP3-13796]](https://resources.bio-techne.com/images/products/Ku80-XRCC5-Antibody-XRCC5-7317-Western-Blot-NBP3-13796-img0001.jpg)

![Immunohistochemistry-Paraffin: Ku80/XRCC5 Antibody (XRCC5/7315) - Azide and BSA Free [NBP3-14017] - Ku80/XRCC5 Antibody (XRCC5/7315) - Azide and BSA Free Immunohistochemistry-Paraffin: Ku80/XRCC5 Antibody (XRCC5/7315) - Azide and BSA Free [NBP3-14017] -](https://resources.bio-techne.com/images/products/nbp3-14017_mouse-ku80-xrcc5-mab-xrcc5-7315-azide-and-bsa-free-24120258203479.jpg)
![Western Blot: Ku80/XRCC5 Antibody (XRCC5/7315) [NBP3-13795] Western Blot: Ku80/XRCC5 Antibody (XRCC5/7315) [NBP3-13795]](https://resources.bio-techne.com/images/products/Ku80-XRCC5-Antibody-XRCC5-7315-Western-Blot-NBP3-13795-img0001.jpg)

![Product Feature: CoraFluor Probes for TR-FRET Ku80/XRCC5 Antibody (XRCC5/8703R) [CoraFluor™ 1]](https://resources.bio-techne.com/images/products/nbp3-21134cl1_rabbit-ku80-xrcc5-mab-xrcc5-8703r-corafluor-1-810202511412010.png)
![Product Feature: CoraFluor Probes for TR-FRET Ku80/XRCC5 Antibody (XRCC5/8093R) [CoraFluor™ 1]](https://resources.bio-techne.com/images/products/nbp3-21133cl1_rabbit-ku80-xrcc5-mab-xrcc5-8093r-corafluor-1-81020251137182.png)